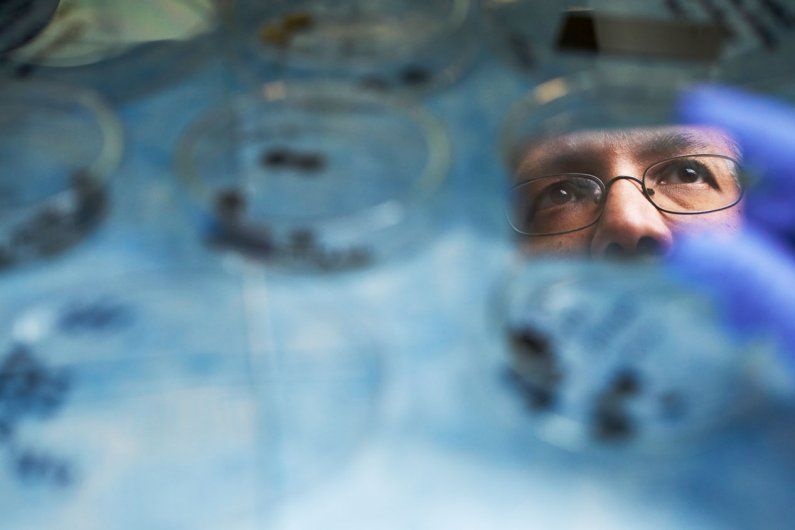

Health and Science
- Aging
- AIDS and HIV
- Alzheimer’s and Dementia
- Arthritis
- Asthma
- Autism and Sensory Processing Disorder
- Biochemistry and Molecular Biology
- Biomedical Engineering
- Biomedical Imaging
- Biotechnology
- Breast Cancer
- Cancer
- Colon and Rectal Cancer
- Consumer Health
- Dentistry and Oral Health
- Dermatology
- Diabetes
- Digital Health
- Drugs and Alcohol
- Emergency Medicine and Trauma Care
- Environmental Sciences
- Epidemiology
- Family Medicine
- Gastroenterology and Hepatology
- Gene Editing and CRISPR
- Genetics and Genomics
- Global Health
- Head, Neck, and Spinal Care
- Health Informatics
- Hearing
- Heart and Vascular
- Hematology
- Homelessness
- Hospital Medicine
- Immunology
- Infectious Disease
- Integrative Medicine
- Leukemia
- Living Therapeutics
- Lung and Pulmonary
- Lung Cancer
- Marijuana and Cannabis
- Mental Health
- Microbiome
- Multiple Sclerosis
- Neurology
- Neurosciences
- Nursing
- Nutrition
- Obesity
- Orthopedics, Sports Medicine and Physical Therapy
- Osteoporosis and Bone Health
- Pain
- Palliative Care
- Pathology
- Pediatrics and Children’s Health
- Pharmacy and Pharmacology
- Precision Medicine and Personalized Medicine
- Prostate Cancer
- Primary Care
- Psychiatry
- Public Health
- Radiology
- Reproductive Health
- Skin Cancer
- Sleep
- Smoking and Tobacco
- Stem Cells
- Stress-Related Conditions
- Stroke and Cerebrovascular Disease
- Surgery
- Technology and AI
- Toxicology
- Transplants
- Urology
- Vision
- Wellness
- Women’s Health